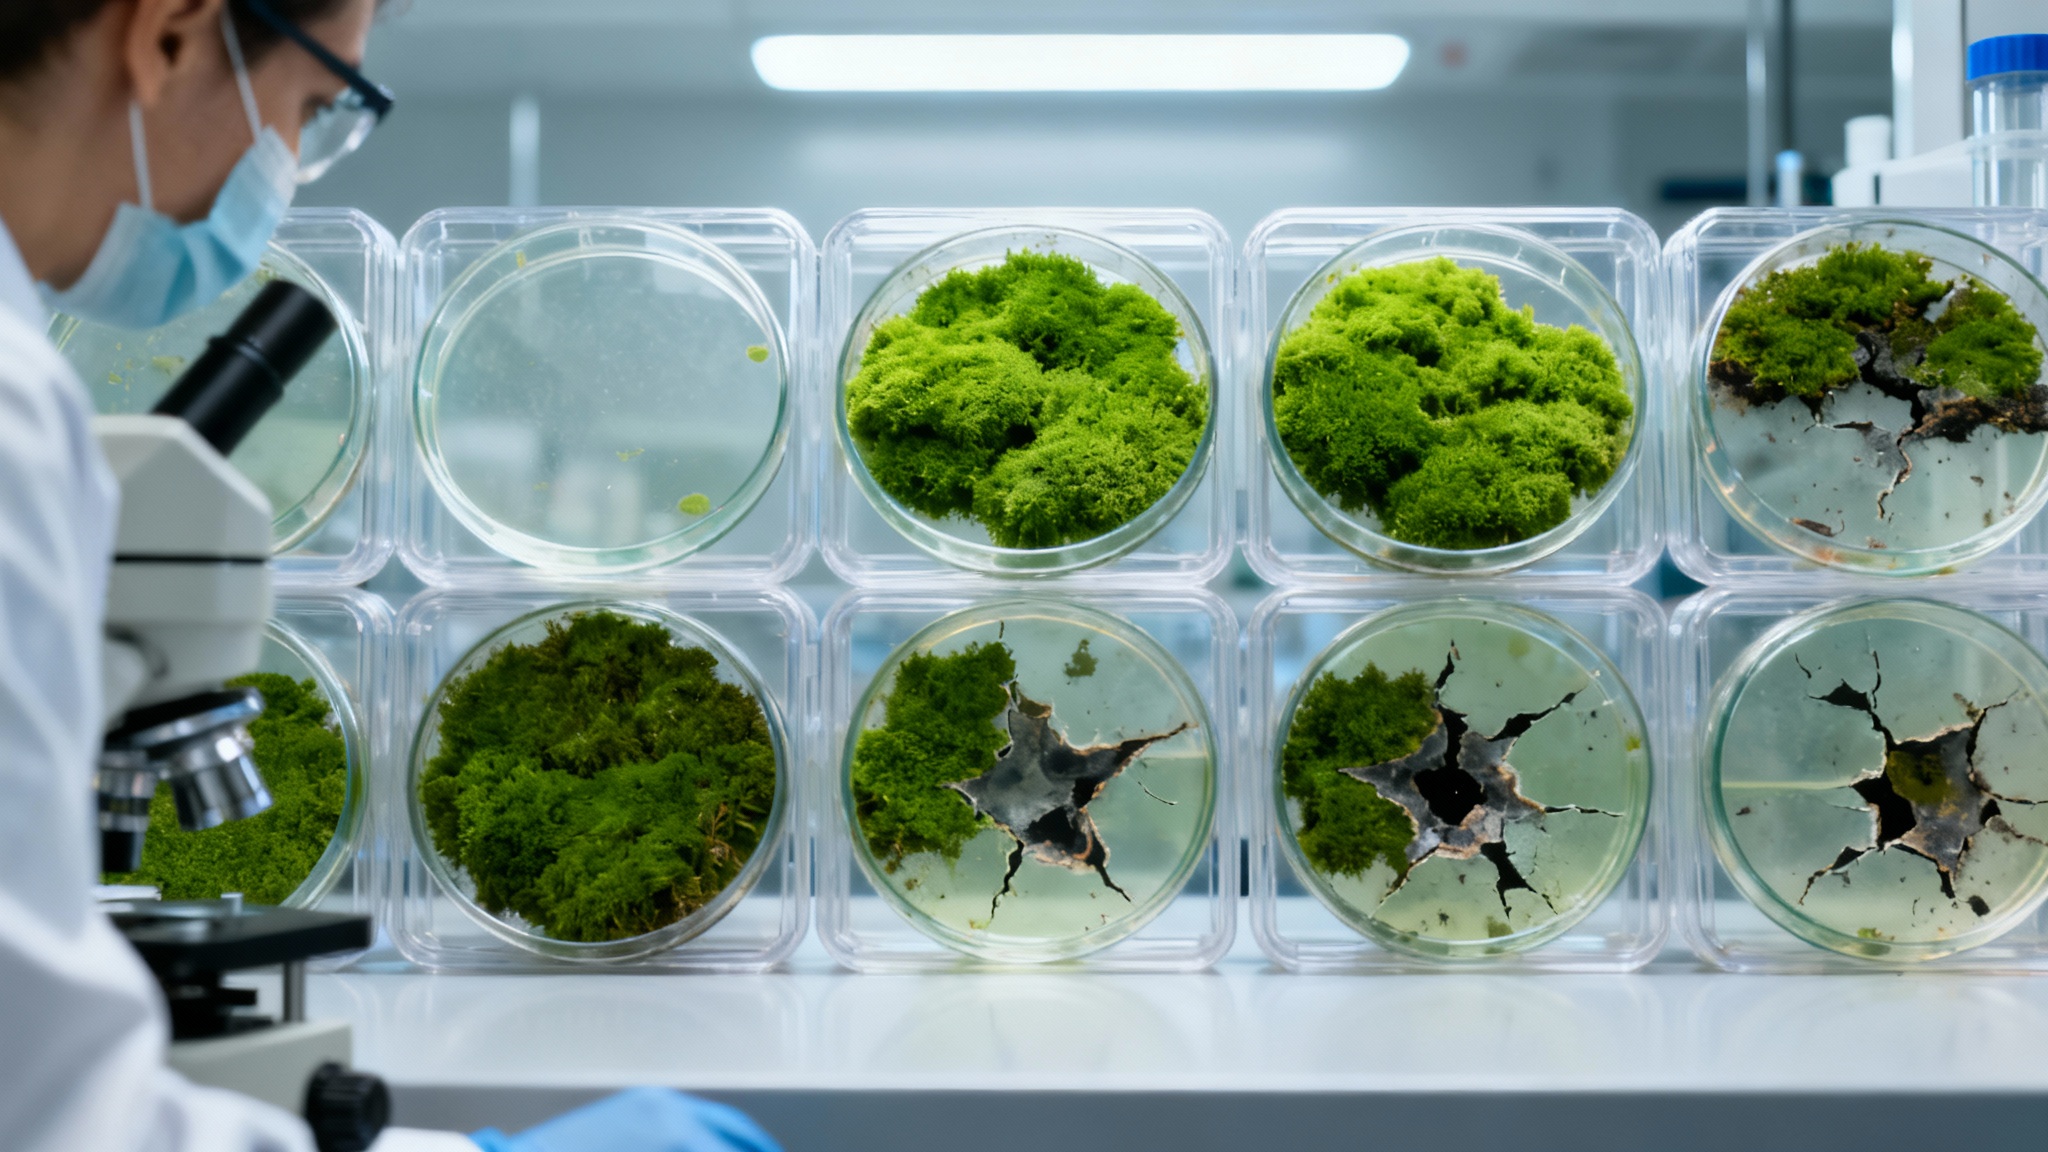

Stupéfiant : des spores de mousse survivent 9 mois dans l’espace et se reproduisent sur Terre
Auteur: Mathieu Gagnon
Un survivant inattendu dans le vide spatial

On pourrait croire que la mousse est une plante délicate, juste bonne à décorer les pieds des arbres. Pourtant, des scientifiques viennent de faire une découverte qui nous a tous laissés bouche bée. Imaginez un peu : des spores de mousse ont passé neuf mois complets à l’extérieur de la Station Spatiale Internationale (ISS). Exposées au vide, aux radiations, au froid glacial… et elles ont survécu.
Mais ce n’est pas tout. Une fois revenues sur notre bonne vieille Terre, elles ont germé comme si de rien n’était. C’est la toute première fois qu’une plante terrestre montre une telle capacité de résistance. Franchement, c’est une sacrée nouvelle.
Pourquoi cette expérience est-elle si importante ?

Si un jour l’humanité décide de s’installer ailleurs que sur notre planète, il faudra bien emporter des formes de vie avec nous. Le problème, c’est que l’espace, ce n’est pas vraiment un environnement accueillant. Nous, les humains, on se protège dans des vaisseaux, mais pour les plantes qui devront un jour pousser sur Mars, par exemple, c’est une autre paire de manches.
Il nous faut trouver des espèces capables de supporter des conditions extrêmes. Et si la modeste mousse était la pionnière qu’il nous fallait ? Après tout, elle a été l’une des premières à conquérir la terre ferme il y a des millions d’années. Peut-être qu’elle pourrait recommencer sur une autre planète.
Les tests en laboratoire : une sélection rigoureuse
Avant d’envoyer quoi que ce soit en orbite (ça coûte une fortune !), l’équipe du professeur Tomomichi Fujita, de l’Université d’Hokkaido, a fait passer un sale quart d’heure à cette mousse, la Physcomitrium patens. Ils l’ont soumise en laboratoire à tout ce que l’espace peut lui faire subir : des températures extrêmes, des rayons UV violents, le vide…
Ils ont testé des jeunes pousses, des cellules spéciales que la plante produit en cas de stress, et des sporophytes, qui sont en gros des capsules remplies de spores. Les jeunes pousses n’ont pas tenu le coup. Les cellules spéciales s’en sont mieux sorties, mais avec beaucoup de pertes. Seuls les sporophytes ont résisté à tout. C’était décidé : c’est eux qui partiraient pour l’ISS.
Le grand test : neuf mois accrochés à l’ISS

Et voilà nos petites spores de mousse attachées à l’extérieur de la station, pour une durée de 283 jours. Presque une grossesse ! Pendant tout ce temps, elles ont tout subi : le vide, les radiations cosmiques, des variations de température incroyables… Bref, le cocktail complet.
Le professeur Fujita l’a dit lui-même : « La plupart des organismes vivants, y compris les humains, ne survivraient pas une seule seconde dans le vide de l’espace ». L’équipe s’attendait honnêtement à un taux de survie proche de zéro. On peut imaginer leur impatience au retour des échantillons…
Des résultats qui dépassent toutes les attentes

Le résultat ? Complètement à l’opposé de ce qu’ils pensaient. « Nous avons été véritablement stupéfaits », a avoué le professeur Fujita. Ce n’est pas une façon de parler. Tenez-vous bien : 86 % des spores exposées à toutes les horreurs de l’espace ont germé une fois de retour sur Terre.
Pour un autre groupe de spores qui avait été protégé des rayons UV mais pas du reste, ce chiffre est même monté à 97 %. C’est la preuve incroyable que la vie terrestre possède, au niveau cellulaire, des mécanismes pour endurer le pire. C’est fou, non ?
Bien sûr, il reste à voir si ce voyage a eu des conséquences à long terme, mais le premier pas est franchi, et quel pas !
Le secret de cette incroyable résistance
Comment une si petite chose peut-elle être aussi solide ? Les scientifiques pensent que le secret réside dans la structure que la mousse construit autour de ses spores. C’est une sorte d’armure naturelle, très efficace pour absorber les rayons UV, par exemple.
Ils supposent que c’est un héritage de l’époque lointaine, il y a 500 millions d’années, où les mousses ont quitté l’eau pour devenir les toutes premières plantes terrestres. À l’époque, la protection contre le soleil était une question de vie ou de mort. Cette vieille armure s’avère aujourd’hui parfaite pour un voyage dans l’espace.
De la mousse sur Mars, et pourquoi pas ?

Cette découverte ouvre des perspectives fascinantes. On se prend à rêver de créer de véritables écosystèmes sur la Lune ou sur Mars, en commençant par ces pionnières végétales. Bien sûr, le chemin est encore long. Survivre au voyage, c’est une chose. S’adapter à un sol inconnu, potentiellement toxique, et à une nouvelle atmosphère, c’en est une autre.
Mais cette petite mousse nous montre que c’est possible. Les chercheurs estiment qu’avec un tel taux de survie, assez de spores pourraient tenir environ 15 ans dans l’espace et encore être capables de démarrer un jardin sur une autre planète. En attendant de pouvoir y faire pousser des pommes de terre, les futurs aventuriers martiens devront peut-être se contenter de soupe à la mousse… Après tout, c’est un plat qui existe vraiment en Islande !
Ce contenu a été créé avec l’aide de l’IA.